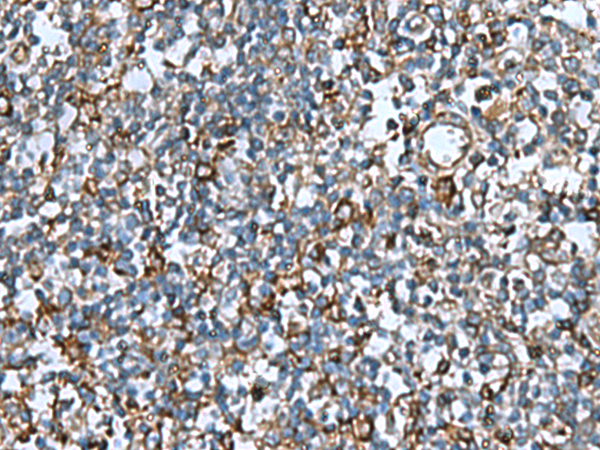

|
Background: |
May modulate activity of cullin-RING E3 ubiquitin ligase (CRL) complexes (PubMed:21778237). May down-regulate activation of NF-kappa-B (PubMed:15799966). Modulates Na+ transport in epithelial cells by regulation of apical cell surface expression of amiloride-sensitive sodium channel (ENaC) subunits (PubMed:23637203). |
|
Applications: |
ELISA, IHC |
|
Name of antibody: |
COMMD9 |
|
Immunogen: |
Fusion protein of human COMMD9 |
|
Full name: |
COMM domain containing 9 |
|
Synonyms: |
HSPC166; C11orf55; LINC00610 |
|
SwissProt: |
Q9P000 |
|
ELISA Recommended dilution: |
5000-10000 |
|
IHC positive control: |
Human cervical cancer and Human tonsil |
|
IHC Recommend dilution: |
50-200 |

購物車
購物車 幫助
幫助
 021-54845833/15800441009
021-54845833/15800441009
